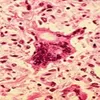
Campak pada Orang Dewasa: Penyakit Masa Kecil yang Bisa Datang Lebih Berat

SURATDOKTER.com - Menjaga agar tubuh menjadi sehat dan juga kuat tentunya kewajiban dari masing-masing manusia itu sendiri.
Makan makanan yang bergizi, olahraga, hingga berbagai hal yang menyehatkan.
Tentunya semua itu dilakukan agar tubuh kita dapat terhindari dari berbagai penyakit yang dapat masuk ke tubuh.
Penyakit sendiri memiliki berbagai kondisi yang harus diwaspadai.
Salah satu penyakit yang tentunya patut diwaspadai yaitu penyakit yang berkaitan dengan seksual.
Dimana penyakit seksual sendiri ada yang menular dan juga yang tidak menular.
Jika kita membahas tentang penyakit seksual tentunya perlunya kita mengenal STD.
Lalu apakah STD ini dan bagaimana gejala hingga penyebabnya, yuk simak pembahasannya dibawah ini
Baca Juga: Ciri-ciri Lidah yang Sehat Seperti Apa? Kenali Jenis Penyakit dan Gangguan Berdasarkan Warnanya
Pengertian STD
STD atau singkatan dari Sexually Transmitted Disease dalam bahasa Indonesia dapat yaitu penyakit menular seksual.
Penyakit ini merupakan salah satu yang patut diwanti-wanti oleh banyak orang.
Dimana dari namanya kita dapat mengartikan bahwa penyakit ini merupakan penyakit yang dapat ditularkan ke orang lain dengan cara berhubungan secara seksual.
Banyak mitos atau berita-berita yang mengabarkan bahwa penyakit satu ini akan sangat berbahaya untuk laki-laki.
Namun dalam faktanya bukan hanya pada laki-laki saja.

Artikel Terkait
Mengenal Virus Hepatitis C: Menyerang Kesehatan Hati
Mengenal Hepatitis B, Ini Gejala, Penyebab serta Pengobatan yang Bisa Dilakukan
Penyakit Raja Singa yang Kerap Menyerang Remaja Pria, Cek Fakta Sifilis dan Kenali Apa itu Titer